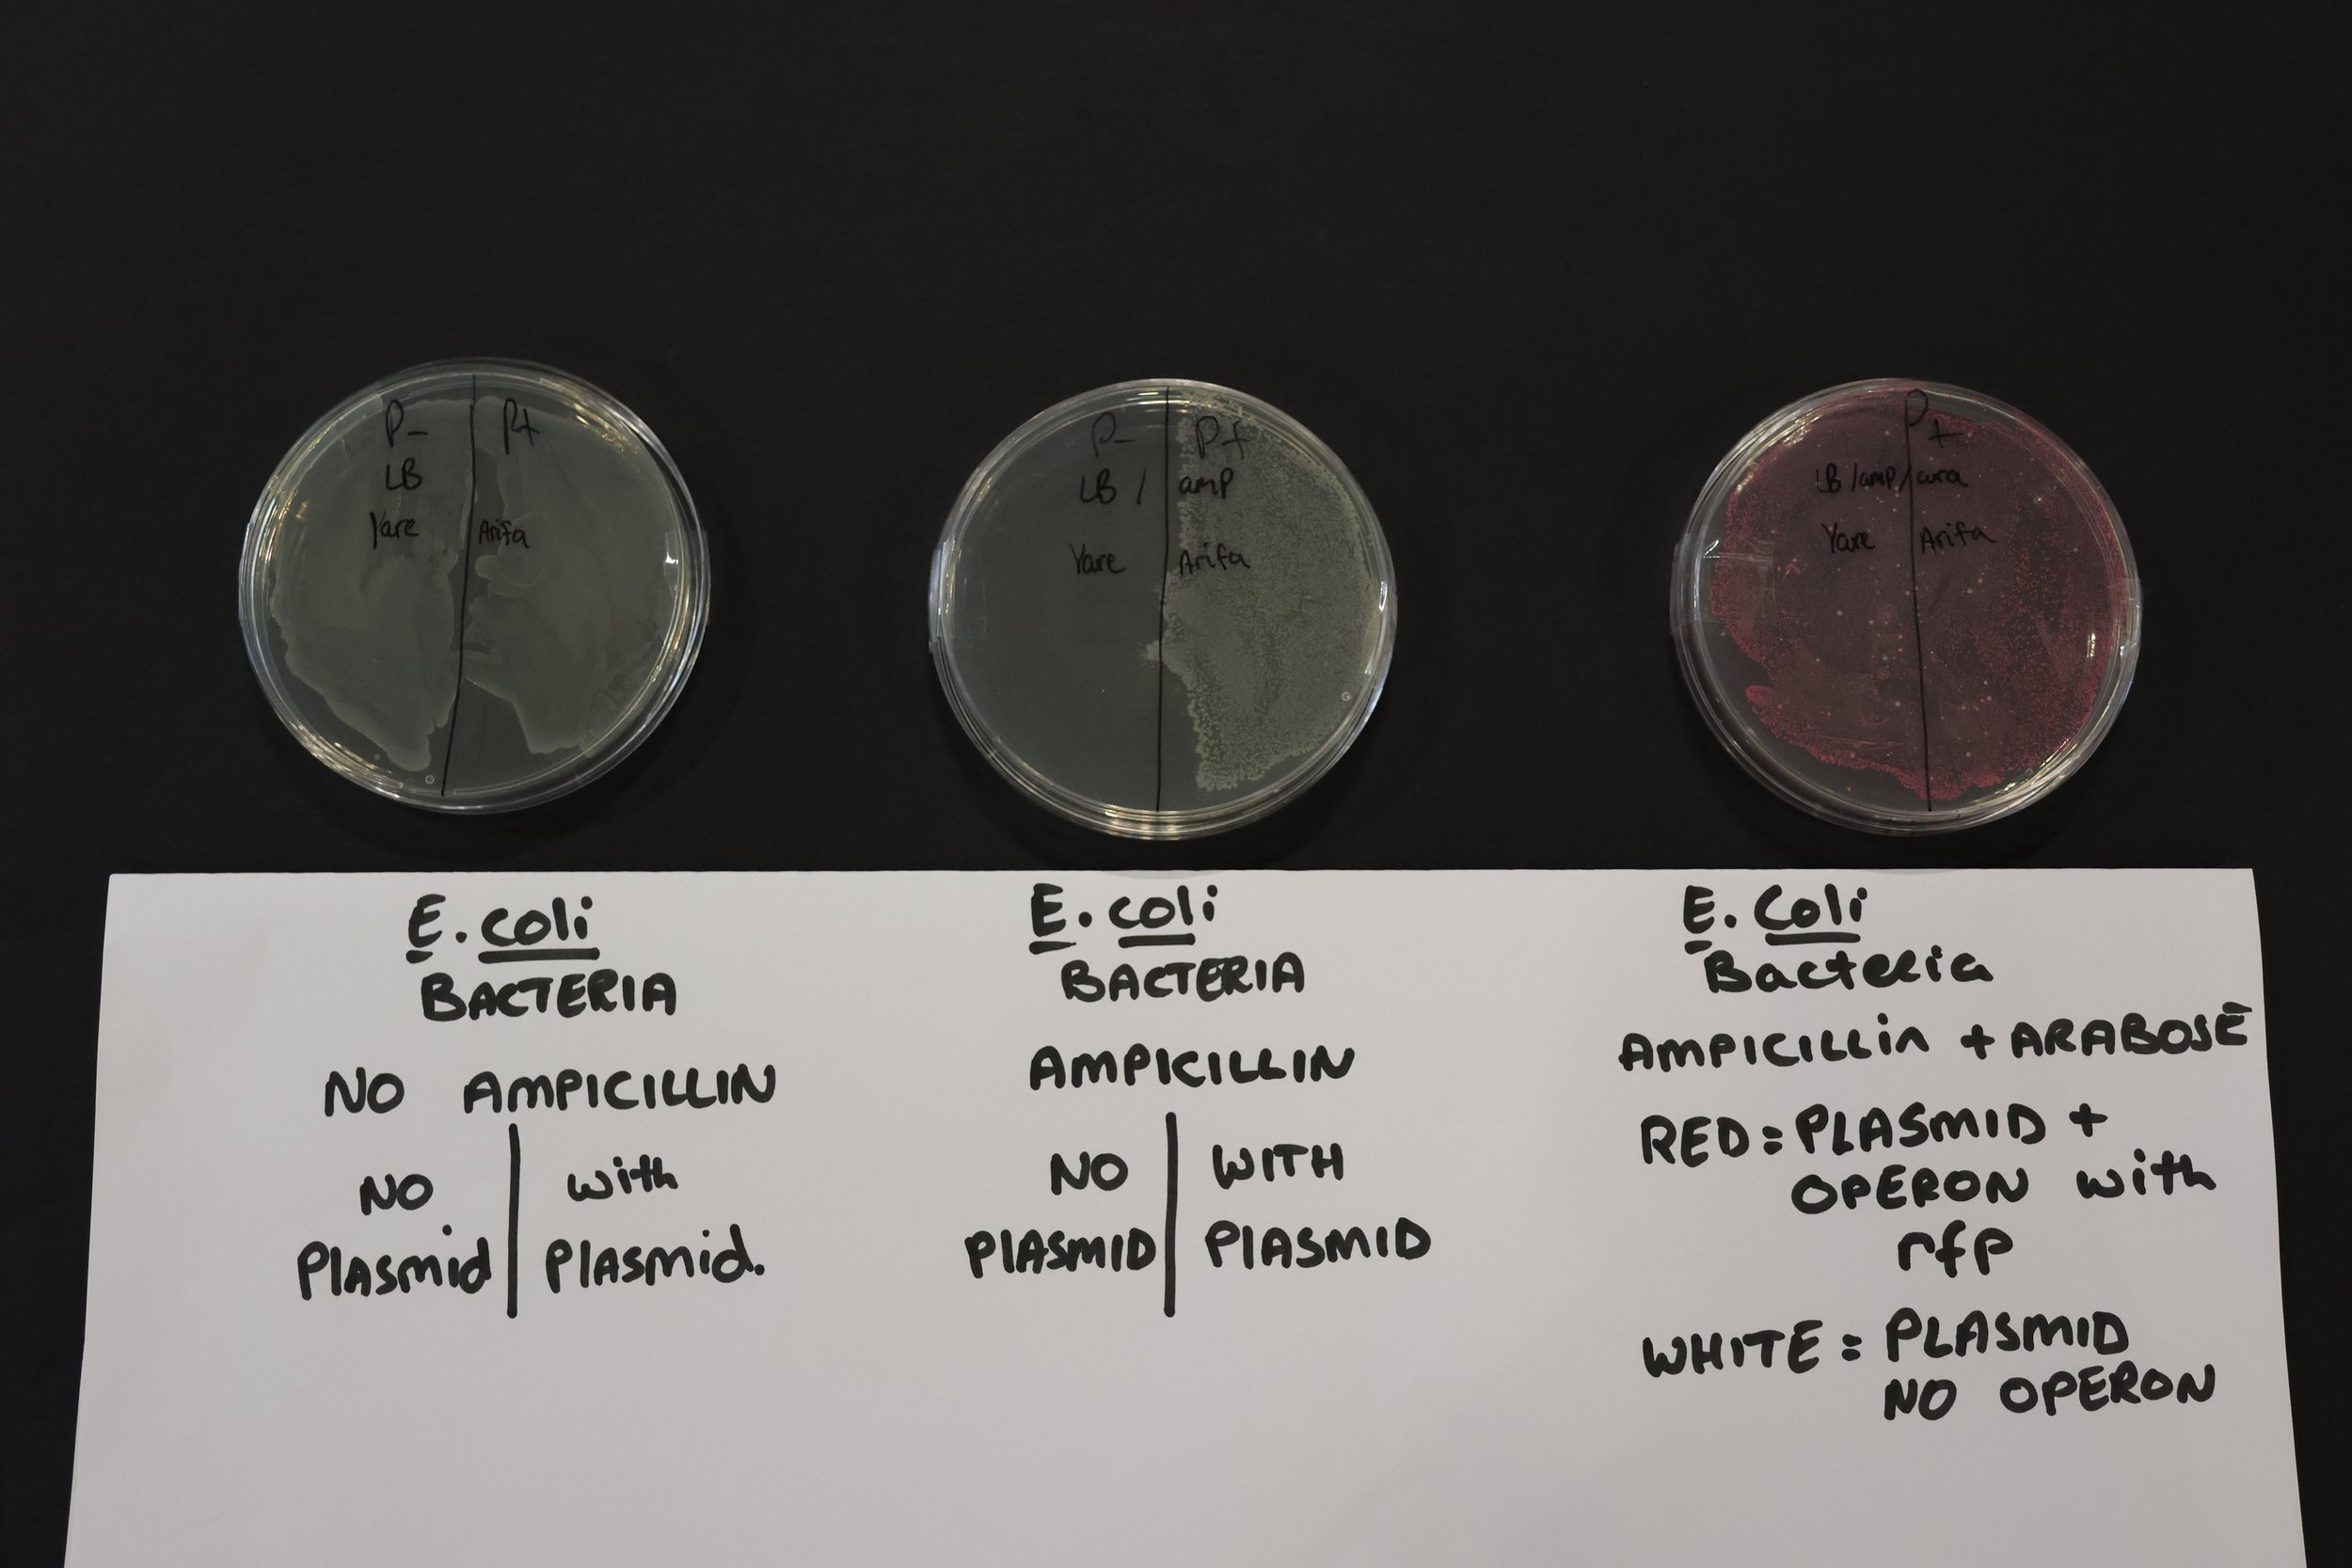
IMG_8236.JPG

Year 13 Students Experience University-Level Biotechnology with the Amgen Biotech Experience
Our Year 13 Biology students recently had the exciting opportunity to take part in the Amgen Biotech Experience, a world-class biotechnology education programme that allows students to explore the techniques used by professional scientists in research laboratories.
During the programme, students worked with cutting-edge biotechnology techniques rarely experienced in secondary schools, gaining hands-on experience with methods normally experienced at university level. The practical sessions focused on the key processes involved in genetic engineering linking to the A level 'Manipulating Genomes' topic, allowing students to apply their theoretical understanding in a real laboratory setting.
Students began by isolating the gene of interest using restriction digestion and Polymerase Chain Reaction (PCR) to produce millions of copies of DNA. They then validated their results using agarose gel electrophoresis, a technique used by scientists to separate and analyse DNA fragments.
After successfully confirming the presence of their DNA fragments, students progressed to the next stage of the experiment: bacterial transformation. They inserted a recombinant plasmid containing a red fluorescent gene into E. coli bacteria, enabling the bacteria to produce a fluorescent protein. This allowed students to see first-hand how genes can be transferred and expressed in living cells — a key principle underpinning modern biotechnology, medicine and genetic research.
The students approached the challenge with great enthusiasm, professionalism and scientific curiosity. Their ability to successfully complete these advanced techniques was truly impressive, and they should be incredibly proud of their work.
Experiences like the Amgen Biotech Experience help students develop practical laboratory skills while giving them insight into the real-world applications of biology, from medical research to biotechnology industries.
Amazing work from our Year 13 biologists!